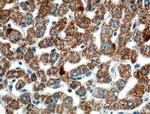
ROCK2(middle) Antibody in Immunohistochemistry (Paraffin) (IHC (P))

Search
Proteintech
ROCK2(middle) Polyclonal Antibody
{{$productOrderCtrl.translations['antibody.pdp.commerceCard.promotion.promotions']}}
{{$productOrderCtrl.translations['antibody.pdp.commerceCard.promotion.viewpromo']}}
{{$productOrderCtrl.translations['antibody.pdp.commerceCard.promotion.promocode']}}: {{promo.promoCode}} {{promo.promoTitle}} {{promo.promoDescription}}. {{$productOrderCtrl.translations['antibody.pdp.commerceCard.promotion.learnmore']}}
产品信息
21645-1-AP
种属反应
已发表种属
宿主/亚型
分类
类型
抗原
偶联物
形式
浓度
规格
纯化类型
保存液
内含物
保存条件
运输条件
产品详细信息
This antibody is specific to ROCK2.
Immunogen sequence: MEIDMTYQL KVIQQSLEQE EAEHKATKAR LADKNKIYES IEEAKSEAMK EMEKKLLEER TLKQKVENLL LEAEKRCSLL DCDLKQSQQK INELLKQKDV LNEDVRNLTL KIEQETQKRC LTQNDLKMQT QQVNTLKMSE KQLKQENNHL MEMKMNLEKQ NAELRKERQD ADGQMKELQD QL (1-181 aa encoded by BC111801)
靶标信息
ROCK2, the predominant ROCK isoform in skeletal muscle, is an important regulator downstream of Rho GTPases. ROCK2 regulates cytokinesis, smooth muscle contraction, the formation of actin stress fibers and focal adhesions, and the activation of the c-fos serum response element. This protein, which is an isozyme of ROCK1 is a target for the small GTPase Rho.
仅用于科研。不用于诊断过程。未经明确授权不得转售。
生物信息学
蛋白别名: p150 ROK-alpha; p164 ROCK-2; Rho kinase 2; Rho-associated coiled-coil forming kinage 2; Rho-associated coiled-coil forming kinase 2; Rho-associated protein kinase 2; Rho-associated, coiled-coil-containing protein kinase 2; Rho-associated, coiled-coil-containing protein kinase II; RhoA - binding serine/threosine kinase alpha (ROK - alpha); RhoA-binding kinase 2; ROCK II; ROCK-II; rockii; ROKalpha; unnamed protein product
基因别名: B230113H15Rik; KIAA0619; mKIAA0619; Rho-kinase; ROCK-II; ROCK2; Rock2m; ROK; ROKalpha
UniProt ID: (Human) O75116, (Rat) Q62868, (Mouse) P70336
Entrez Gene ID: (Human) 9475, (Rat) 25537, (Mouse) 19878